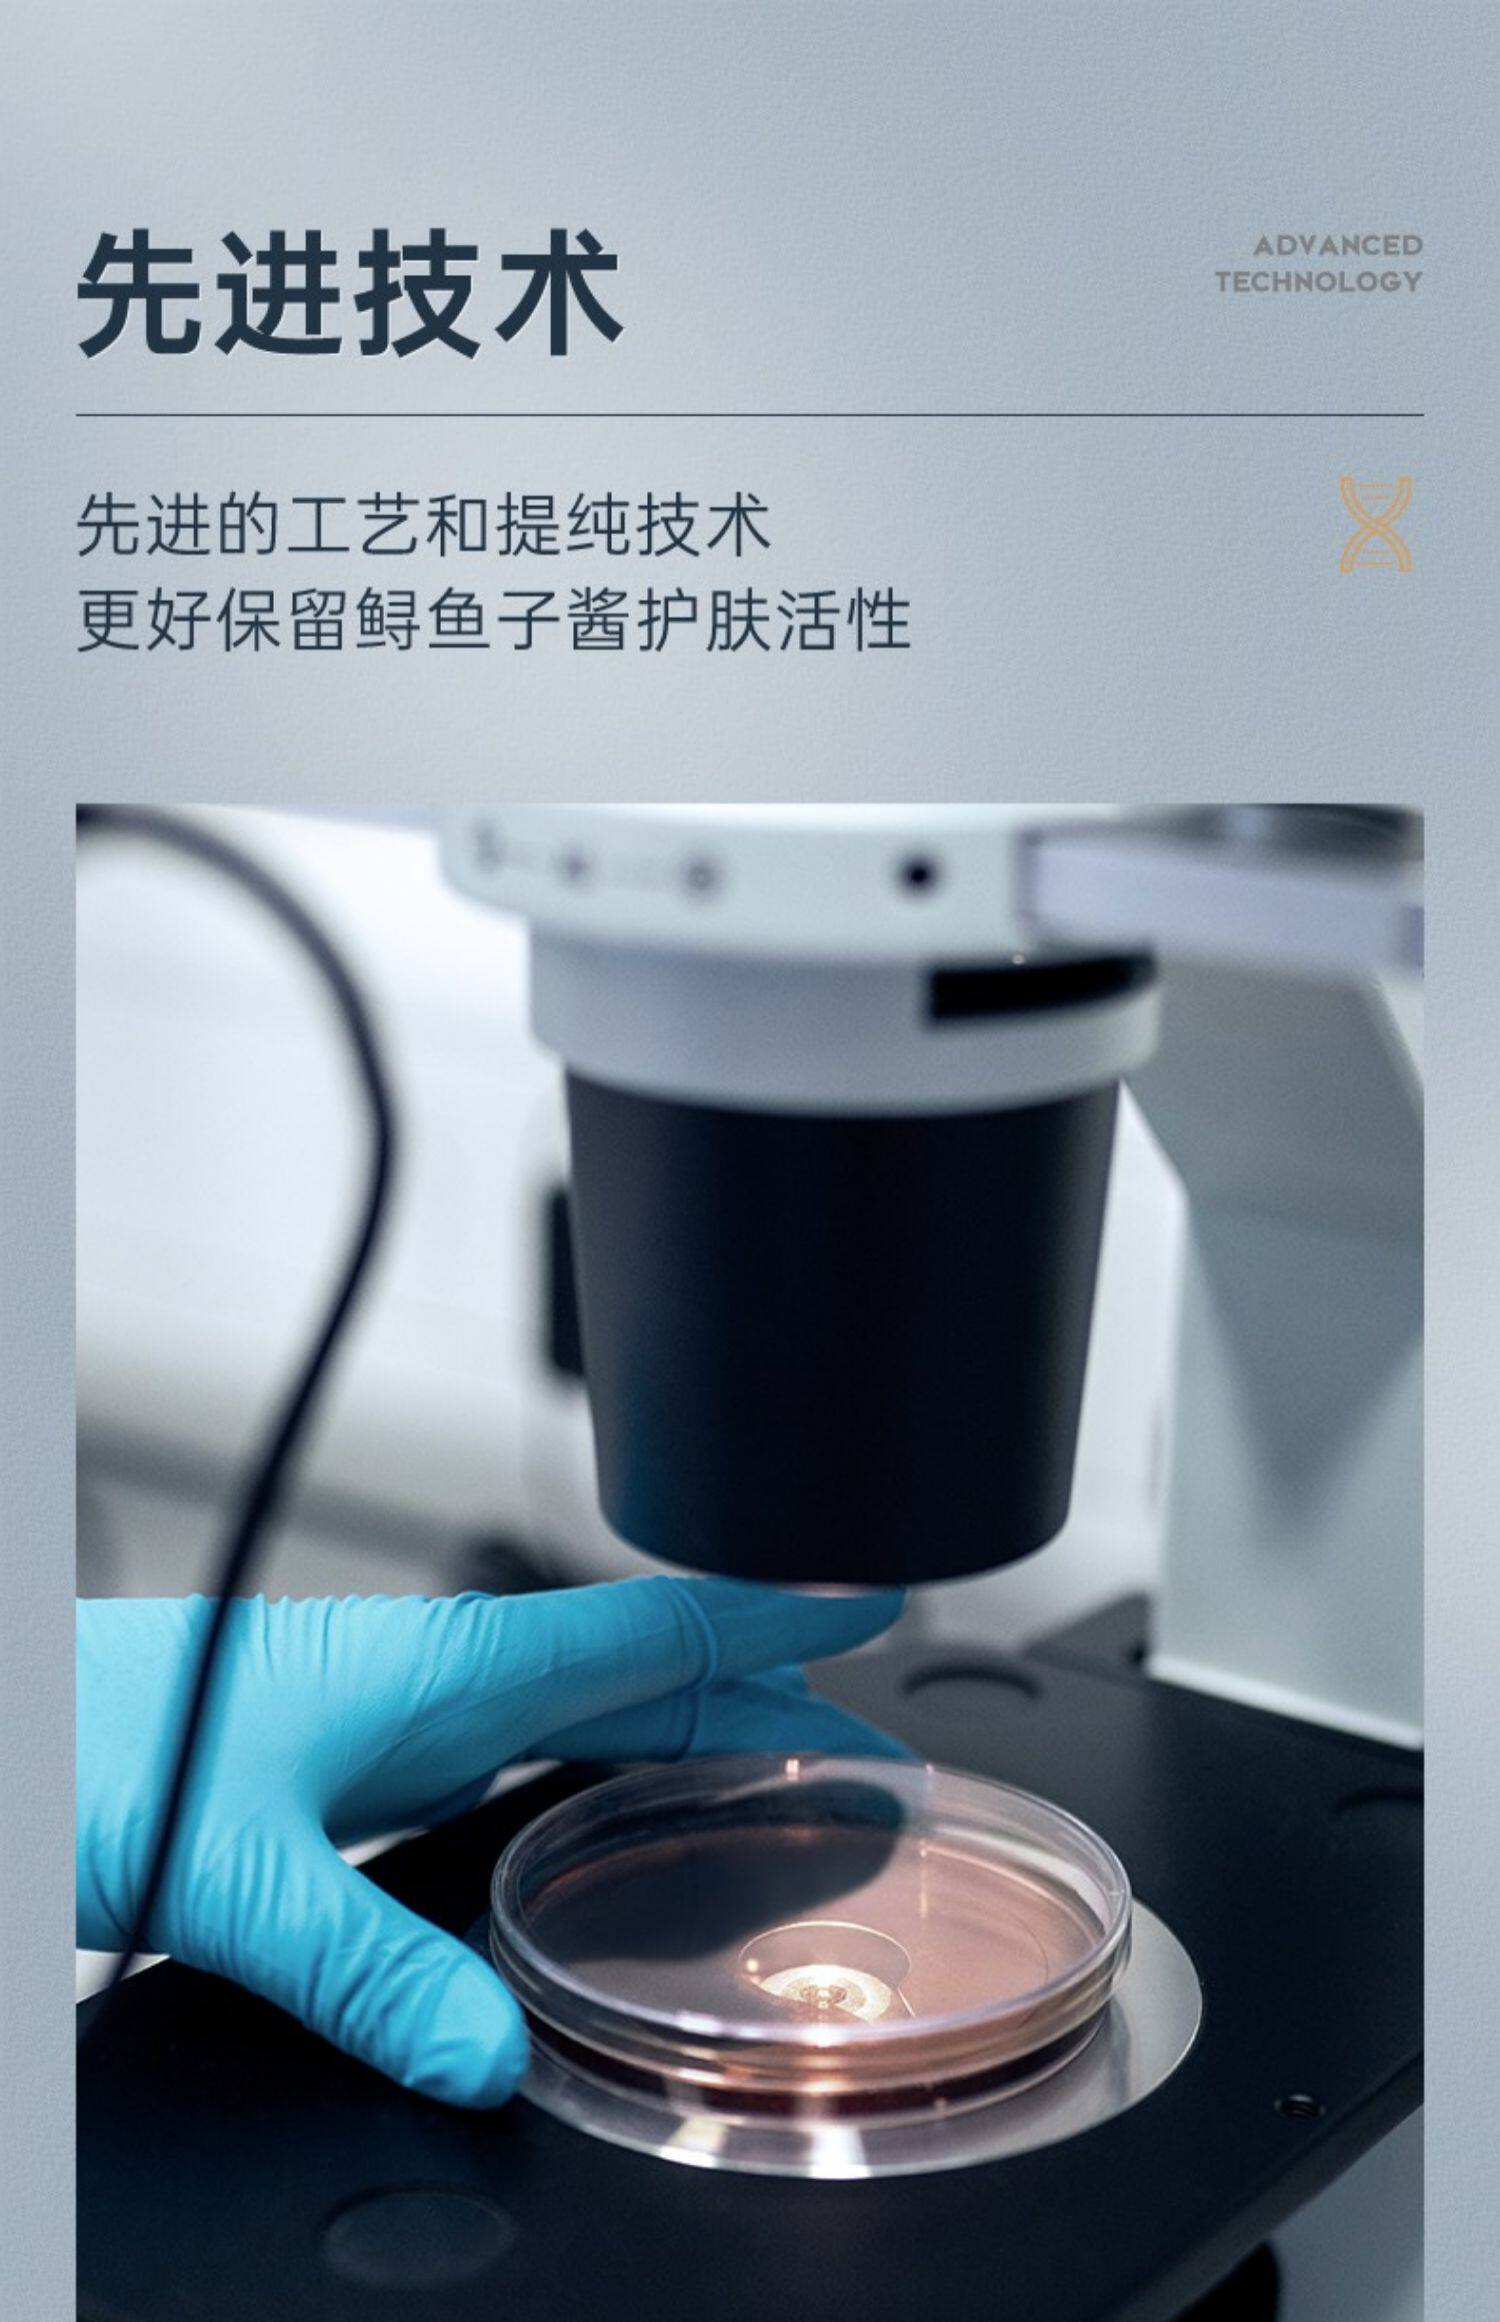

Демисезонный увлажняющий питательный вазелин, крем для тела против сухости, лосьон для всего тела, против зуда

Цена: 2 111руб. (¥99.9)
Артикул: 657911653704
Вес товара: ~0.7 кг. Указан усредненный вес, который может отличаться от фактического. Не включен в цену, оплачивается при получении.
Описание товараPGRpdj48aW1nIHNyYz0iaHR0cHM6Ly9pbWcuYWxpY2RuLmNvbS9pbWdleHRyYS9pMS9PMUNOMDFSUlU4MlcxTU1QQU9ZbkJvZl8hITYwMDAwMDAwMDE0MjAtMi10cHMtMTEyNS0yMzEucG5nIj48L2Rpdj48ZGl2PjxpbWcgc3JjPSJodHRwczovL2ltZy5hbGljZG4uY29tL2ltZ2V4dHJhL2kyLzY5MzA2Mjk5NS9PMUNOMDFDWUhUOE8xWHprdnFiUkZDN18hITY5MzA2Mjk5NS5qcGciPjwvZGl2PjxkaXY+PGltZyBzcmM9Imh0dHBzOi8vaW1nLmFsaWNkbi5jb20vaW1nZXh0cmEvaTQvNjkzMDYyOTk1L08xQ04wMXU4TTh0eTFYemt3MVd0ZTZhXyEhNjkzMDYyOTk1LmpwZyI+PC9kaXY+PGRpdj48aW1nIHNyYz0iaHR0cHM6Ly9pbWcuYWxpY2RuLmNvbS9pbWdleHRyYS9pNC82OTMwNjI5OTUvTzFDTjAxQjFUb3VvMVh6a3Z0T0xQSmtfISE2OTMwNjI5OTUuanBnIj48L2Rpdj48ZGl2PjxpbWcgc3JjPSJodHRwczovL2ltZy5hbGljZG4uY29tL2ltZ2V4dHJhL2kxLzY5MzA2Mjk5NS9PMUNOMDFYMU9sbEkxWHprdm04NjFsMV8hITY5MzA2Mjk5NS5qcGciPjwvZGl2PjxkaXY+PGltZyBzcmM9Imh0dHBzOi8vaW1nLmFsaWNkbi5jb20vaW1nZXh0cmEvaTEvNjkzMDYyOTk1L08xQ04wMWgzTlVtbjFYemt2cDRaV3I1XyEhNjkzMDYyOTk1LmpwZyI+PC9kaXY+PGRpdj48aW1nIHNyYz0iaHR0cHM6Ly9pbWcuYWxpY2RuLmNvbS9pbWdleHRyYS9pMy82OTMwNjI5OTUvTzFDTjAxZTljR294MVh6a3ZyRThJTGJfISE2OTMwNjI5OTUuanBnIj48L2Rpdj48ZGl2PjxpbWcgc3JjPSJodHRwczovL2ltZy5hbGljZG4uY29tL2ltZ2V4dHJhL2kxLzY5MzA2Mjk5NS9PMUNOMDFoVkxvNVkxWHprdnFibXZWcV8hITY5MzA2Mjk5NS5qcGciPjwvZGl2PjxkaXY+PGltZyBzcmM9Imh0dHBzOi8vaW1nLmFsaWNkbi5jb20vaW1nZXh0cmEvaTQvNjkzMDYyOTk1L08xQ04wMWlZSURrODFYemt2dkdJVjcwXyEhNjkzMDYyOTk1LmpwZyI+PC9kaXY+PGRpdj48aW1nIHNyYz0iaHR0cHM6Ly9pbWcuYWxpY2RuLmNvbS9pbWdleHRyYS9pMy82OTMwNjI5OTUvTzFDTjAxTFVEWGI4MVh6a3ZnZ3NQcGxfISE2OTMwNjI5OTUuanBnIj48L2Rpdj48ZGl2PjxpbWcgc3JjPSJodHRwczovL2ltZy5hbGljZG4uY29tL2ltZ2V4dHJhL2kzLzY5MzA2Mjk5NS9PMUNOMDFWenBLdnAxWHprdno0MHJidV8hITY5MzA2Mjk5NS5qcGciPjwvZGl2PjxkaXY+PGltZyBzcmM9Imh0dHBzOi8vaW1nLmFsaWNkbi5jb20vaW1nZXh0cmEvaTQvNjkzMDYyOTk1L08xQ04wMXVYczJtODFYemt2cDRZZW52XyEhNjkzMDYyOTk1LmpwZyI+PC9kaXY+PGRpdj48aW1nIHNyYz0iaHR0cHM6Ly9pbWcuYWxpY2RuLmNvbS9pbWdleHRyYS9pMS82OTMwNjI5OTUvTzFDTjAxNUcyM2Q4MVh6a3cxV3RlODBfISE2OTMwNjI5OTUuanBnIj48L2Rpdj48ZGl2PjxpbWcgc3JjPSJodHRwczovL2ltZy5hbGljZG4uY29tL2ltZ2V4dHJhL2kxLzY5MzA2Mjk5NS9PMUNOMDF3RVo2RXgxWHprdnRMbkliOF8hITY5MzA2Mjk5NS5qcGciPjwvZGl2PjxkaXY+PGltZyBzcmM9Imh0dHBzOi8vaW1nLmFsaWNkbi5jb20vaW1nZXh0cmEvaTMvNjkzMDYyOTk1L08xQ04wMTJTdkRCTTFYemt2cWJucmlZXyEhNjkzMDYyOTk1LmpwZyI+PC9kaXY+PGRpdj48aW1nIHNyYz0iaHR0cHM6Ly9pbWcuYWxpY2RuLmNvbS9pbWdleHRyYS9pMy82OTMwNjI5OTUvTzFDTjAxOVN0NDZVMVh6a3Z1eElwTzBfISE2OTMwNjI5OTUuanBnIj48L2Rpdj48ZGl2PjxpbWcgc3JjPSJodHRwczovL2ltZy5hbGljZG4uY29tL2ltZ2V4dHJhL2k0LzY5MzA2Mjk5NS9PMUNOMDFYUkxTYngxWHprdnRMcDZ4bF8hITY5MzA2Mjk5NS5qcGciPjwvZGl2PjxkaXY+PGltZyBzcmM9Imh0dHBzOi8vaW1nLmFsaWNkbi5jb20vaW1nZXh0cmEvaTEvNjkzMDYyOTk1L08xQ04wMVRRSE1lUDFYemt2ejQwYXZuXyEhNjkzMDYyOTk1LmpwZyI+PC9kaXY+PGRpdj48aW1nIHNyYz0iaHR0cHM6Ly9pbWcuYWxpY2RuLmNvbS9pbWdleHRyYS9pMi82OTMwNjI5OTUvTzFDTjAxOW4yWElpMVh6a3ZsREFxRW1fISE2OTMwNjI5OTUuanBnIj48L2Rpdj48ZGl2PjxpbWcgc3JjPSJodHRwczovL2ltZy5hbGljZG4uY29tL2ltZ2V4dHJhL2kzLzY5MzA2Mjk5NS9PMUNOMDFIY1plSmUxWHprdmxEOUliSl8hITY5MzA2Mjk5NS5qcGciPjwvZGl2PjxkaXY+PGltZyBzcmM9Imh0dHBzOi8vaW1nLmFsaWNkbi5jb20vaW1nZXh0cmEvaTEvNjkzMDYyOTk1L08xQ04wMUwzVFFxYjFYemt3MVd1bXBVXyEhNjkzMDYyOTk1LmpwZyI+PC9kaXY+PGRpdj48aW1nIHNyYz0iaHR0cHM6Ly9pbWcuYWxpY2RuLmNvbS9pbWdleHRyYS9pMi82OTMwNjI5OTUvTzFDTjAxb0xsdlVnMVh6a3Z3UXI3MVdfISE2OTMwNjI5OTUuanBnIj48L2Rpdj48ZGl2PjxpbWcgc3JjPSJodHRwczovL2ltZy5hbGljZG4uY29tL2ltZ2V4dHJhL2kyLzY5MzA2Mjk5NS9PMUNOMDE1OUVyTzgxWHprdnZHSDl5ZF8hITY5MzA2Mjk5NS5qcGciPjwvZGl2PjxkaXY+PGltZyBzcmM9Imh0dHBzOi8vaW1nLmFsaWNkbi5jb20vaW1nZXh0cmEvaTIvNjkzMDYyOTk1L08xQ04wMVVFMFl3aTFYemt2dkdJbGtJXyEhNjkzMDYyOTk1LmpwZyI+PC9kaXY+PGRpdj48aW1nIHNyYz0iaHR0cHM6Ly9pbWcuYWxpY2RuLmNvbS9pbWdleHRyYS9pNC82OTMwNjI5OTUvTzFDTjAxc29tNmdPMVh6a3cxV3Q2cHJfISE2OTMwNjI5OTUuanBnIj48L2Rpdj48ZGl2PjxpbWcgc3JjPSJodHRwczovL2ltZy5hbGljZG4uY29tL2ltZ2V4dHJhL2kxLzY5MzA2Mjk5NS9PMUNOMDFTVENPc1cxWHprdzBvVHpjdF8hITY5MzA2Mjk5NS5qcGciPjwvZGl2PjxkaXY+PGltZyBzcmM9Imh0dHBzOi8vaW1nLmFsaWNkbi5jb20vaW1nZXh0cmEvaTQvNjkzMDYyOTk1L08xQ04wMThRZGVoczFYemt2ckU4dG81XyEhNjkzMDYyOTk1LmpwZyI+PC9kaXY+PGRpdj48aW1nIHNyYz0iaHR0cHM6Ly9pbWcuYWxpY2RuLmNvbS9pbWdleHRyYS9pMS82OTMwNjI5OTUvTzFDTjAxRVVSR2oyMVh6a3Z0TG1VaDNfISE2OTMwNjI5OTUuanBnIj48L2Rpdj48ZGl2PjxpbWcgc3JjPSJodHRwczovL2ltZy5hbGljZG4uY29tL2ltZ2V4dHJhL2k0LzY5MzA2Mjk5NS9PMUNOMDFlZ3phN2wxWHprdmM1cDhQR18hITY5MzA2Mjk5NS5qcGciPjwvZGl2PjxkaXY+PGltZyBzcmM9Imh0dHBzOi8vaW1nLmFsaWNkbi5jb20vaW1nZXh0cmEvaTQvNjkzMDYyOTk1L08xQ04wMWdPYkcxbDFYemt3MG9XZzRvXyEhNjkzMDYyOTk1LmpwZyI+PC9kaXY+PGRpdj48aW1nIHNyYz0iaHR0cHM6Ly9pbWcuYWxpY2RuLmNvbS9pbWdleHRyYS9pMi82OTMwNjI5OTUvTzFDTjAxRThFSjZUMVh6a3ZyRUFaZzFfISE2OTMwNjI5OTUuanBnIj48L2Rpdj48ZGl2PjxpbWcgc3JjPSJodHRwczovL2ltZy5hbGljZG4uY29tL2ltZ2V4dHJhL2kxLzY5MzA2Mjk5NS9PMUNOMDFsRlY5NXAxWHprdndRcEFVNF8hITY5MzA2Mjk5NS5qcGciPjwvZGl2PjxkaXY+PGltZyBzcmM9Imh0dHBzOi8vaW1nLmFsaWNkbi5jb20vaW1nZXh0cmEvaTMvNjkzMDYyOTk1L08xQ04wMUlpbnNmejFYemt2a00yeUpDXyEhNjkzMDYyOTk1LmpwZyI+PC9kaXY+PGRpdj48aW1nIHNyYz0iaHR0cHM6Ly9pbWcuYWxpY2RuLmNvbS9pbWdleHRyYS9pNC82OTMwNjI5OTUvTzFDTjAxNEdDMmJhMVh6a3Z3UXEyWEZfISE2OTMwNjI5OTUuanBnIj48L2Rpdj48ZGl2PjxpbWcgc3JjPSJodHRwczovL2ltZy5hbGljZG4uY29tL2ltZ2V4dHJhL2kxLzY5MzA2Mjk5NS9PMUNOMDFmbHpDSlAxWHprdnRPTm96Yl8hITY5MzA2Mjk5NS5qcGciPjwvZGl2PjxkaXY+PGltZyBzcmM9Imh0dHBzOi8vaW1nLmFsaWNkbi5jb20vaW1nZXh0cmEvaTIvNjkzMDYyOTk1L08xQ04wMXhyTW1KZjFYemt2a00zTkl5XyEhNjkzMDYyOTk1LmpwZyI+PC9kaXY+PGRpdj48aW1nIHNyYz0iaHR0cHM6Ly9pbWcuYWxpY2RuLmNvbS9pbWdleHRyYS9pMi82OTMwNjI5OTUvTzFDTjAxelRsaFNyMVh6a3Z2R0dEaVZfISE2OTMwNjI5OTUuanBnIj48L2Rpdj48ZGl2PjxpbWcgc3JjPSJodHRwczovL2ltZy5hbGljZG4uY29tL2ltZ2V4dHJhL2k0LzY5MzA2Mjk5NS9PMUNOMDF0TGU4bWkxWHprdnR6NTBadl8hITY5MzA2Mjk5NS5qcGciPjwvZGl2PjxkaXY+PGltZyBzcmM9Imh0dHBzOi8vaW1nLmFsaWNkbi5jb20vaW1nZXh0cmEvaTQvNjkzMDYyOTk1L08xQ04wMTdQQ0o1RTFYemt2cDRZTzdyXyEhNjkzMDYyOTk1LmpwZyI+PC9kaXY+PGRpdj48aW1nIHNyYz0iaHR0cHM6Ly9pbWcuYWxpY2RuLmNvbS9pbWdleHRyYS9pMy82OTMwNjI5OTUvTzFDTjAxWXZmYldHMVh6a3Z0TGxEaGhfISE2OTMwNjI5OTUuanBnIj48L2Rpdj48ZGl2PjxpbWcgc3JjPSJodHRwczovL2ltZy5hbGljZG4uY29tL2ltZ2V4dHJhL2k0LzY5MzA2Mjk5NS9PMUNOMDEzV1BsbU4xWHprdnRPTFBJWV8hITY5MzA2Mjk5NS5qcGciPjwvZGl2Pg==
Продавец:旺仔铺11
Рейтинг:

Всего отзывов:0
Положительных:0
Выберите вариацию / цвет
- Ароматный
Выберите размер / комплектацию
- 300ml
Добавить в корзину
- Информация о товаре
- Фотографии
| Чистый контент: | 300ml |
| Аромат: | Ароматный |